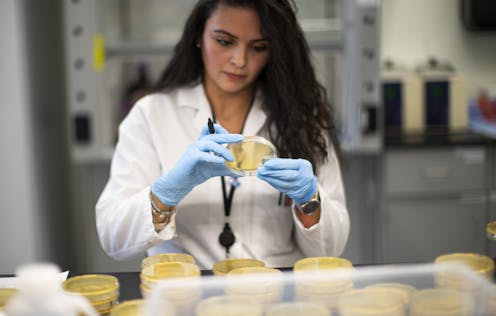

Could pressure for COVID-19 drugs lead the FDA to lower its standards?
The FDA has sped up its approval process for coronavirus treatments, creating a new division to expedite the regulatory process. But is safety being sidelined for speed?
Given the death, suffering, social disruption and economic devastation caused by COVID-19, there is an urgent need to quickly develop therapies to treat this disease and prevent the spread of the virus.
But the Food and Drug Administration, charged with the task of evaluating and deciding whether to approve new drugs and other products, has a problem. The FDA’s standards appear to be dropping at a time when rigorous regulatory review and robust oversight are crucial.
For example, on March 28, the FDA granted emergency use authorization (EUA) for chloroquine phosphate and hydroxychloroquine sulfate, despite the drugs having known safety concerns and negligible evidence of efficacy in treating COVID-19.
As a specialist in bioethics and public health, I see troubling signs that suggest the FDA’s new program for expediting reviews of potential therapies for COVID-19 is not working as it should. Instead, its regulatory oversight has been weakened. In its place, I see signs of political interference, inappropriate pressure to authorize products for emergency use, and an overwhelming surge of clinical studies that challenges the FDA’s capacity to carefully scrutinize them before deciding whether they should proceed.
Are the right people doing the work?
Even with numerous special approval programs in existence, it typically takes about eight years for new drugs to proceed from initial authorization of clinical trials to FDA approval. Because the process of testing drugs and other potential therapies can be so lengthy, the pandemic poses a challenge to the FDA’s usual review and approval processes.
In response to COVID-19, the FDA established the Coronavirus Treatment Acceleration Program (CTAP) to expedite the regulatory review process and help facilitate the speedy development of treatments and preventive measures.
The FDA has redeployed many staff members to serve on CTAP review teams. In public statements about CTAP, the FDA has not disclosed how many staff members serve on these teams. And it’s not certain if all reassigned staff members have the background and training required to review COVID-19 studies and individual patient requests for expanded access to investigational new drugs. There is little publicly available information concerning how CTAP is staffed, how review teams have been organized, and what kinds of expertise particular teams of reviewers possess.
If FDA employees are being assigned unfamiliar responsibilities, or are reviewing applications for products beyond their expertise, there’s a risk those reviews will not be sufficiently thorough.
CTAP is essentially an opaque regulatory initiative. Decisions emerge from CTAP but we don’t know who made them, why they were made, or what information was provided to FDA. While some details have been shared, I believe that, in general, CTAP would benefit from greater transparency.
A 24-hour review
The FDA, claiming to cut red tape, says it’s now reviewing many clinical study protocols for COVID-19 within 24 hours. But what specific bureaucratic impediments did the FDA eliminate to fast-track the process? That we don’t know. In public statements about CTAP, the FDA hasn’t identified what “bureaucratic impediments” it removed. The agency has yet to disclose this important information.
What we do know: The FDA has enabled COVID-19 studies to proceed at a far more rapid pace than trials that are testing interventions for other diseases. By doing so, the FDA needs to respond to scientists, physicians, bioethicists, regulatory specialists and other critics concerned that the FDA is failing to maintain its regulatory standards.
Mounting evidence indicates CTAP’s oversight may be inadequate. One example: The FDA has cleared an application for a clinical study to test a stem cell product to see if it’s safe and if it works. The stem cells, researchers hope, will provide enough immune support to reduce symptoms and hospitals stays for COVID-19. But the study has no control group that can be used to compare the stem cell intervention against a placebo or sham procedure.
Without such a control group, the study will not generate usable data concerning whether or not the administered stem cells are effective.
Because of how little information has been disclosed about CTAP’s operation, the inner workings of CTAP seem beyond public scrutiny. No information is available on why some trials were cleared to proceed despite what many researchers would consider glaring shortcomings. This includes poor study design, small sample size, substantial overlap with other studies, or as in case of the stem cell study, a lack of a control group.
That specific problematic trials are being allowed to proceed within a wider climate of disrespect for evidence-based clinical research adds to the concern. Many scientists fear that President Trump’s boosterism for drugs he believes prevent or treat COVID-19 has helped to undermine the independence and integrity of FDA decision-making. The FDA’s emergency use authorization for hydroxychloroquine sulfate and chloroquine phosphate only heightened the concern. The independence of the FDA is also in question amid efforts to develop safe and effective vaccines for COVID-19.
Need for transparency grows as trials expand
The agency has indicated that summary statistics about CTAP will be forthcoming. So far, however, the FDA has only disclosed limited information about the program’s operations. Meanwhile, the number of trials allowed to proceed – and need for oversight – has grown.
When the creation of CTAP was announced on March 31, the FDA said clinical trials had begun for 10 therapeutic agents to treat COVID-19, with 15 more in planning stages. The FDA now reports that by mid-April, it had received 950 inquiries and proposals concerning COVID-19 related drug development. By May 11, 144 active trials of therapeutic agents were in progress, or cleared to proceed. Another 457 development programs for therapeutic agents were in planning stages.
It is good to have such information in the public domain. However, I believe the public deserves to know much more about how CTAP is functioning. Along with providing regular updates on the number of COVID-19 applications it has received, and the number cleared to proceed, the FDA needs to report the number of proposed studies it has declined to review; the number of times the FDA has not cleared studies to proceed and has instead imposed holds due to safety issues; and the duration between when investigational new drug applications were submitted and when the studies were allowed to proceed or placed on hold.
Most importantly, the public needs to know more about how decisions are being made within CTAP. Public understanding of CTAP would increase if the FDA identified the clinical studies it reviews and clears, and provided links to listings on ClinicalTrials.gov.
The FDA’s commissioner has defended the agency’s practices during the pandemic, including the use of less “robust” datasets. But the FDA’s review process needs to result in the development of safe and effective COVID-19 treatments. Speed of product development, while crucial in a pandemic, must never be prioritized over all other considerations. Political pressure cannot influence regulatory decision-making; the agency must release more information about CTAP’s review standards and decision-making processes. First and foremost, the FDA’s rigorous oversight – rather than a race to satisfy an aggressive and perhaps political agenda – is imperative during this pandemic.
[Get facts about coronavirus and the latest research. Sign up for The Conversation’s newsletter.]
Leigh Turner does not work for, consult, own shares in or receive funding from any company or organization that would benefit from this article, and has disclosed no relevant affiliations beyond their academic appointment.
Read These Next
In war-torn Iran, air pollution from burning oil depots and bombed buildings unleashes invisible hea
The damage from military attacks on cities can fill the air with pollutants that harm the lungs and…
The first modern rocket launched 100 years ago, beginning a century of both innovations and challeng
From World War II to the Apollo era, the space shuttle program and today’s privately developed commercial…
A writing professor’s new task in the age of AI: Teaching students when to struggle
How do instructors get students to trust their own thinking and be better than robots?



